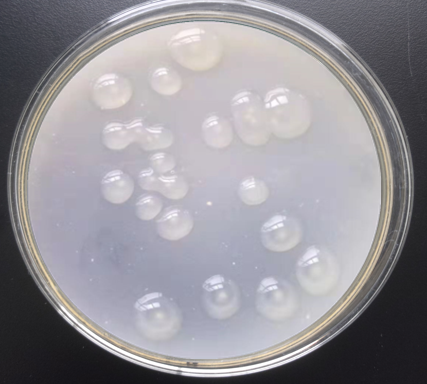

Bacillus mucilaginosus
I. Brief introduction:
Bacillus mucilaginosus can multiply and grow in soil, produce metabolites such as organic acids and capsule polysaccharides, destroy the lattice structure of silica-aluminate and insoluble phosphorus compounds, decompose and release soluble phosphorus, potassium, calcium, sulfur, magnesium, iron, zinc, molybdenum, manganese and other medium and trace elements, improve soil fertility and provide nutrients for crops. At the same time, gibberellin, indoleacetic acid, cytokinin and other physiological active substances are produced to promote nutrient absorption and metabolism of crops.
II. Product function:
1. Decompose phosphorus and potassium, fix nitrogen. Effectively improve fertilizer utilization rate and reduce fertilizer consumption.
2. Activate and loosen soil. Decompose silicon, calcium, sulfur, boron, molybdenum, zinc and other medium and trace elements. Provide nutrients for plants.
3. Produce gibberellin, indoleacetic acid, cytokinin and other physiological activators. Promote plant growth robust. Enhance cold resistance, drought resistance, disease resistance and cultivation resilience. Improve product quality and yield.
4. The formation of beneficial flora in the roots of crops can effectively inhibit the breeding of harmful pathogenic microorganisms, thus significantly reducing the use of pesticides.
5. Decomposition and regulation of various nutrient elements can effectively prevent the occurrence of physiological nutrient deficiency symptoms in plants.
III. Specification:
|
Attribute Name |
Attribute data |
|
Appearance |
White powder (not deliquesous and caked) |
|
Specification/Model |
5 billion/g、 10 billion/g 、Customization is acceptable |
|
Water content |
≤ 6% |
|
Grain size (through 60 mesh screen) |
≥95% |
IV. Usage: Usage and dosage (5 billion /g powder as an example)
1. Bacillus mucilaginosus can be directly applied to a variety of plants. It can be used as base fertilizer, topdressing fertilizer, seed fertilizer or seed immersion.
a. Base fertilizer: Apply 1-2 kg of ditch fertilizer per mu/666.67m2. Cover the soil after fertilizing. If used together with farm fertilizer, the effect will be better.
b. Seed mixing agent: Mix the Bacillus mucilaginosus with an appropriate turbid liquid. Spray on the seeds and mix well. Sow immediately after the seeds have dried slightly.
c. Dipping root: The Bacillus mucilaginosus was mixed with water in a ratio of 1:5. After the clear liquid is clarified. The roots of rice, vegetables and other crops are immersed in the clear liquid. Protect the roots from direct sunlight.
d.As a bacterial agent, the dosage per mu/666.67m2 is 75~100g. User can adjust the dosage according to the specific situation.
2.Bacillus mucilaginosus can be mixed with compound microbial fertilizer, microbial fertilizer and bio-organic fertilizer.
|
Specification |
667Square meter |
With other fertilizers(1 T) |
|
5 billion /g |
1-2 kg |
40-50 kg |
|
10billion /g |
0.5-1 kg |
20-25 kg |
Caution
1、 It can not be used with fungicides, antibiotics, disinfectants at the same time.
2、 After opening the bag or bucket. If not used up, please tie the bag mouth or tighten the bucket cover. So as to avoid the inactivation of active ingredients.
VI. Storage:
It Should be stored in a cool, dry, well-ventilated place. Prevent direct sunlight, heat and humidity. Avoid storing with toxic and harmful substances.
VII. Warranty period:
The shelf life of product is 12 months in a cool and dry environment.
VIII. Packing:
20kg/bag, 25kg/bag Or according to customization
IX. Technical support and service:
Technical support services will be provided throughout the process by XINGTAI SINOBEST BIOTECH CO., LTD. Our professional technicians will ensure that each customer will be under the correct guidance to use this product.
X. Precaution:
Although this product is non-toxic and biodegradable, it may induce sensitization and cause anaphylactic reactions in sensitized individuals. Direct contact with the human body should be avoided because prolonged exposure may cause minor irritation to the skin, eyes or nasal mucous membranes. Seeking medical attention if skin or eye irritation or allergic reactions occur.
Hits:1895 Entry time:2023-01-09 20:00:42【Print this page】【return】